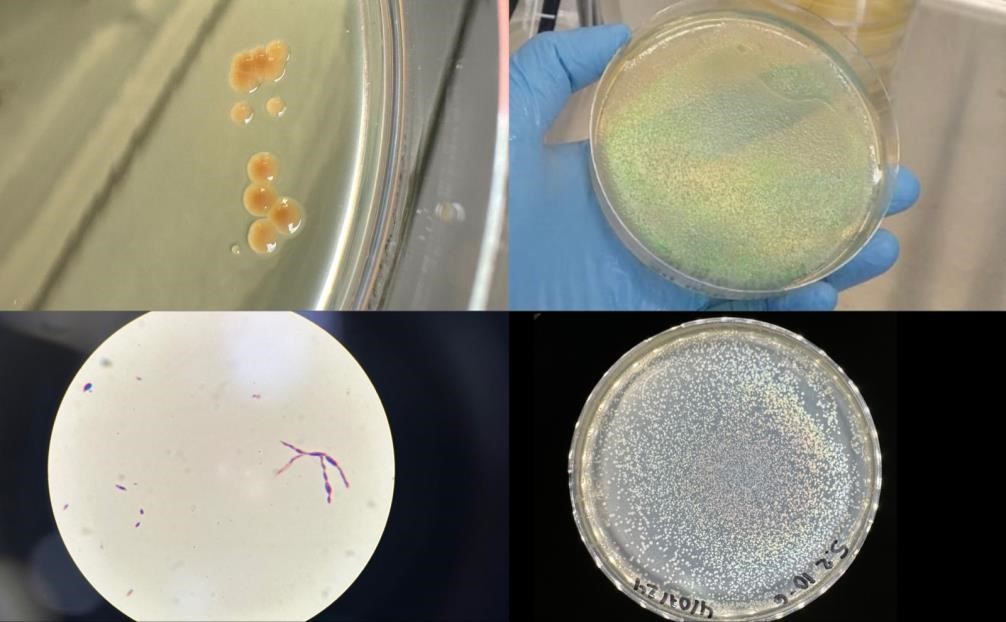

DIVERSIDAD BIOLÓGICA Y POTENCIAL BIORREMEDIADOR DE MICROORGANISMOS AMBIENTALES
Alejandra Melgar-Valeriano¹, Andrés S. Ortiz-Morazán¹, ²
¹Escuela de Microbiología, Facultad de Ciencias, Universidad Nacional Autónoma de Honduras, Tegucigalpa, Honduras
²Instituto de Investigación de Microbiología
Autor de correspondencia: Andrés Ortiz - aortizm@unah.edu.hn
INTRODUCCIÓN
El uso de microorganismos biorremediadores tiene un gran potencial como una posible solución para disminuir la contaminación ambiental causada por el uso de pesticidas y otros contaminantes provenientes de la industria [1,2]. Una de las estrategias para aislar microorganismos con este potencial es evaluar diferentes muestras ambientales con el objetivo de identificar microorganismos con características particulares y seleccionar aquellos con mayor potencial para su uso en procesos de biorremediación.
METODOLOGÍA
Se recolectaron un total de 74 muestras ambientales provenientes de parques nacionales, reservas forestales, aguas termales, suelos y aguas de minas. Para el procesamiento de estas muestras, se realizaron diluciones seriadas y posteriormente se sembró por la técnica de extensión en superficie en agar Luria-Bertani (LB), incubando por dos semanas a una temperatura de 25-26°C. Las colonias obtenidas fueron purificadas y caracterizadas morfológica y bioquímicamente. Posteriormente, se realizó una extracción de ADN por el método CTAB [3] y se amplificaron con cebadores específicos para estos microorganismos.
RESULTADOS
Se aislaron un total de 116 cepas, de las cuales 59 eran bacilos Gram negativos, 28 bacilos Gram positivos, 8 cocos Gram positivos y 16 cocos Gram negativos (Figura 1). Por otro lado, cinco de estas cepas mostraron características poco comunes en su morfología colonial y celular. Una presentó pigmento rosa, característico de Methylobacterium sp.; dos cepas presentaron pigmento verde metálico y dos presentaron iridiscencia. Se observaron características metabólicas particulares que han sido descritas previamente en microorganismos con potencial biorremediador [4,5]. La mayoría de las cepas presentaron un rápido crecimiento a temperatura de 25-26°C y un bajo crecimiento a 37°C.
Figura 1. Mapa de distribución de los sitios de colecta de muestras.
A
D
C
B
Figura 2. A. Cepa con presencia de pigmento rosa. B. Cepa con presencia de pigmento verde metálico. C. Morfología colonial atípica observada con tinción de Gram. D. Cepa con iridiscencia.
CONCLUSIÓN
Se observó una gran diversidad de microorganismos con características genéticas y fenotípicas que sugieren un potencial biorremediador. Sin embargo, es necesario continuar realizando pruebas específicas para evaluar su capacidad y posible aplicación. Se recomienda ampliar el número de sitios de muestreo para continuar aislando cepas con estas características.
REFERENCIAS
1. Ocampo Hernández CE. El potencial de la biorremediación. Herreriana. 2021;2(2).
2. Garzón JM, Rodríguez Miranda JP, Hernández Gómez C. Aporte de la biorremediación para solucionar problemas de contaminación y su relación con el desarrollo sostenible. Univ Salud. 2017;19(2).
3. Doyle JJ. Isolation of plant DNA from fresh tissue. Focus (Madison). 1990;12.
4. Rodríguez-Gonzales A, Zárate-Villarroe SG, Bastida-Codina A. Biodiversidad bacteriana presente en suelos contaminados con hidrocarburos para realizar biorremediación. Revista de Ciencias Ambientales. 2022;56(1).
5. Tsagkari E, Sloan WT. Impact of Methylobacterium in the drinking water microbiome on removal of trihalomethanes. Int Biodeterior Biodegradation. 2019;141.
Cómo citar este trabajo (Vancouver):
Melgar-Valeriano A, Ortiz-Morazán AS. DIVERSIDAD BIOLÓGICA Y POTENCIAL BIORREMEDIADOR DE MICROORGANISMOS AMBIENTALES [resumen]. En: Vispo NS, editor. Memorias del Congreso de Investigación y Posgrado UNAH 2024: Libro de resúmenes. Madrid/Tegucigalpa: Clinical Biotec S.L.; Universidad Nacional Autónoma de Honduras; 2024. doi: 10.70099/cb/unah/2024.mem
ISBN del libro: 978-84-09-76685-7